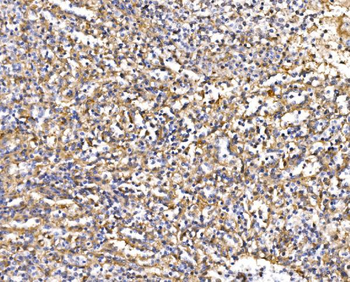

You have no items in your shopping cart.
Cart summary

Squalene
Catalog Number: orb105024
| Catalog Number | orb105024 |
|---|---|
| Category | Small Molecules |
| Description | Squalene |
| CAS Number | [7683-64-9] |
| Purity | > 98%,Standard References |
| MW | 410.72 |
| SMILES | C/C(C)=CCC/C(C)=C/CC/C(C)=C/CC/C=C(CC/C=C(C)CC/C=C(C)C)C |
| Formula | C30H50 |
| Note | For research use only |
| Expiration Date | 12 months from date of receipt. |
Anti-SNAP23 Antibody [orb1152313]
ELISA, FC, ICC, IF, IHC, WB
Human
Rabbit
Polyclonal
Unconjugated
10 μg, 100 μgAnti-NEFL/NF-L Antibody [orb738390]
ELISA, FC, IF, IHC, WB
Human, Mouse, Rat
Rabbit
Polyclonal
Unconjugated
10 μg, 100 μgAnti-Epac1/RAPGEF3 Antibody [orb763139]
ELISA, FC, ICC, IF, IHC, WB
Human, Monkey, Mouse
Rabbit
Polyclonal
Unconjugated
10 μg, 100 μg